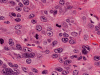

| A 60 year-old Man with a
Nodule at the Tip of the Nose. May, 2008, Case 805-1. Home Page |
Katerine Seywerd, M.D., Elizabeth Gillies, M.D., Kar-Ming Fung, M.D., Ph.D. Last update: June 1, 2008.
Department of Pathology, University of Oklahoma Health Sciences Center, Oklahoma City, Oklahoma
Clinical information: The patient was a 60 year-old man who came to our clinic with the complain of a nodule a the tip of the nose. On physical examination, a 1.2 cm firm nodule was found at the tip of the nose. The nodule is firmly fixed to the underlying tissue and is covered by intact skin. The nodule was excised and yielded the following representative images.
Pathology of the Case: The tumor is covered by
intact epidermis (Panel
A)
and surrounded the underlying septal cartilage (Panel
B).
On medium magnification, the tumor is composed of nests of cells that have
features of squamous cells. A variable number of mucin producing cells that vary
from single cell to small cell nests are present among the squamous cells
(Panel
C,
D, and
E).
In some areas, the squamous differentiation is slightly obscure.The tumor cells
are pleomorphic and mitotic figures are common (Panel
F).
Small mucin containing microcysts are found in some area (Panel
G and
H).
The overall distribution of the aforementioned histologic components is uneven
within the tumor. Individual and nests of mucin producing cells are well
highlighted by mucicarmine stain (Panel
I).

A
B
C
D
E
F




G
H
Scanned slide
Mucicarmine
Scanned slide
| DIAGNOSIS: Mucoepidermoid carcinoma, intermediate grade. |
Discussion:
General Information
As a general rule, malignant tumors of the nasal cavity are rare. In considering the differential diagnosis it should include squamous cell carcinoma, adenocarcinoma, undifferentiated carcinoma, melanoma, lymphoma and mucoepidermoid carcinoma. Most commonly encountered is squamous cell carcinoma, which itself can be easily confused with the aggressive high grade mucoepidermoid carcinoma in the unwary.
Mucoepidermoid carcinoma is a frequently occurring malignant tumor in the head and neck region. Among the major salivary glands, the parotid gland is most commonly involved 1. It is also the most frequently diagnosed malignancy in the minor salivary glands of the oral cavity and pharynx, and the lacrimal glands 2. Mucoepidermoid carcinoma of the nasal cavity, however, is rare and most likely arising from the minor salivary gland. As in our case, the overly epidermis is intact. The most likely origin of the tumor is the minor salivary gland at the tip of the nose. A combined report of four large series of major and minor salivary glands indicate that sinonasal mucoepidermoid carcinoma accounts for 0.6 % of all salivary gland tumors and 4.8% of all mucoepidermoid carcinomas 3. When such tumors arise in the sinonasal tract it is most commonly seen in the maxillary antrum. Other sites, in order of decreasing incidence, include the nasal cavity, nasopharynx and ethmoid sinuses 2. This pattern is likely a reflection of the relative distribution of minor salivary glands in the upper aerodigestive tract. When arising in the parotid gland it occurs most frequently between the third and the forth decade, with a mean age of 49 years 1. It occurs 1.7 more times in female patients than in males. Due to its rarity in the sinonasal tract no strong data exists regarding its sex and age distribution.
Sinonasal tract adenomatous tumors have been presumed to arise from submucosal mucoserous glands. More specifically, it is thought to arise from the pluripotent cells of the excretatory ducts of the salivary gland which have potential to differentiate into squamous, columnar and mucous cells 1, 4. Studies one by Gnepp and Heffner on the mucosal origin of 107 sinonasal tract adenomatous tumors contradict this belief. This study found that most (including 83 % of mucoepidermoid carcinomas) originated from the surface mucosa 2. Additionally, the mucoepidermoid carcinomas in their series were often seen to occur in association with adjacent dysplastic surface mucosa 2. Their findings suggest that mucoepidermoid carcinoma of the sinonasal tract, similar the squamous cell carcinoma, can be preceded by mucosal dysplasia or carcinoma in situ. No definitive risk factors for mucoepidermoid carcinoma have been identified, although minor trauma and chronic irritation have been found to be implicated in the general etiology of sinonasal tract cancers 2. It has also been suggested that prior exposure to ionizing radiation, with latency periods ranging from 7 to 32 years, may play a role 1. No definitive evidence points toward cigarette smoking as a causative factor in sinonasal carcinomas.
The symptoms and clinical findings of mucoepidermoid carcinoma of the sinonasal tract are variable and may include epistaxis, facial pain, diplopia and/or a subcutaneous mass if there has been erosion of bone and invasion into the subcutis. It is very important that the early management of such patients involves the use of CT to determine the presence of a neoplasm and once documented an MRI should be carried out to assess for the presence of intracranial extension. The reasoning behind this is that this neoplasm develops in the submucosal region and has a strong propensity to infiltrate and proliferate even when the mucosal surface remains smooth. Macroscopic determination of the degree of infiltration is thus very difficult.
Genetics
At present the most common chromosomal translocation to be described in mucoepidermoid carcinoma is the t(11;19)(q21;p13). (6) It involves the mucoepidermoid carcinoma translocated 1 (MECT1) gene and a member of the mastermind-like gene family (MAML2) 5, 6. The result of this translocation is the generation of MECT1-MAML2 chimeric gene which acts to disrupt the normal mechanism of the Notch signaling pathway. The end result is that the Notch-target genes are activated independently of exogenous signals 6.
Pathology:
Mucoepidermoid carcinoma can be low-grade, intermediate grade, or high-grade. In general, low-grade tumors tend to be cystic or multicystic. Intermediate or high-grade tumors are usually solid. The proportion of mucin secreting cells decreases in higher histologic grades and their distribution is uneven throughout the tumor. Therefore, intermediate and high-grade tumors may be misdiagnosed as squamous cell carcinoma easily. A high index of suspicion is necessary to avoid this diagnostic pitfall.
Histologically, mucoepidermoid carcinoma is comprised of three cell types which are squamous epithelium, mucus secreting cells and intermediate cells. Intermediate cells are round to ovoid and smaller than the classic squamous cells in squamous cell carcinoma and they often looks like immature squamous epithelial cells. The squamous cells may closely resemble or indistinguishable from those of classic squamous cell carcinoma. For mucus secreting cells that contains a substantial amount of mucus, they do not typically appear high grade. The distribution of these three types of cells is typically uneven throughout the tumor and therefore thorough sampling is mandatory.
The criteria used to define and grade a mucoepidermoid carcinoma include
Presence of a combination of mucous, intermediate and squamous cells.
Proportion of solid and cystic growth patterns.
Degree of nuclear atypia.
Presence or absence of neural invasion.
Presence or absence of necrosis.
Mitotic rate.
Mucous cells may be difficult to identify due to their scarcity, but their presence is required for the diagnosis. In cases suspicious of mucoepidermoid carcinoma but no obvious mucous secreting cells are found, mucicarmine stain is helpful in highlighting these cells. Entrapped mucus secreting cells should not be confused with neoplastic mucin secreting cells. Clear cells may be present and often contain glycogen and they appear like altered squamous cells.
Low grade is comprised primarily of mucous cells and the absence of nuclear atypia. Because of their cystic nature, they can be misdiagnosed as benign mucinous cyst. Generous examination of the specimen can avoid this pitfall. A predominantly solid growth pattern, predominance of squamous cells, intermediate cells, is consistent with intermediate grade and mild atypia is typically present. The intermediate grade can easily be misdiagnosed as squamous cell carcinoma because of their solid nature and, sometimes, paucity of mucin secreting cells. High grade is suggested by moderate to high nuclear pleomorphism within a predominantly squamous cell population, peirneural invasion, necrosis and a high mitotic rate.
Prognosis and Treatment:
Compared with low-grade tumor, the high grade tumor is more invasive and has a stronger tendency towards distant of lymphatic metastases. As a result it is advocated that low-grade tumors are managed with surgical resection alone. For intermediate or high-grade tumors complete resection with post-operative radiation are recommended. Clinical nodal disease should be treated with appropriate neck dissection and post-operative radiotherapy. The low number of reported cases of sinonasal mucoepidermoid carcinoma has not allowed for an adequate assessment of the role of chemotherapy in these patients.
In terms of the outcome of all mucoepidermoid carcinomas of the head and neck region the 10 year cure rate for low-grade is approximately 90 % and for high-grade is approximately 40 % Other factors which have been predictive of poor 5 year survival include bone invasion, age greater than 60 years and positive cervical nodes.Reference:
Boahene DK, Olsen KD, Lewis JE, Pinheiro AD, Pankratz VS, Bagniewski SM. Mucoepidermoid Carcinoma of the Parotid Gland. Arch Otolaryngol Head Neck Surg 2004130:849-856.
Thomas GR, Regalado JJ, McClinton M. A rare case of mucoepidermoid carcinoma of the nasal cavity. Ear Nose Throat J 2002 81:519-30.
Simpson RJ, Hoang KG, Hyams VJ, Jarchow RC. Mucoepidermoid carcinoma of the maxillary sinus. Otolaryngol Head Neck Surg 1988 99:419-23.
Rahbar R, Grimmer JF, Vargas SO, Robson CD, Mack JW, Perez-Atayde AR, Marcus KJ, Grier HE, Healy GB, McGill TJ. Mucoepidermoid Carcinoma of the Parotid gland in Children. Arch Otolaryngol Head Neck Surg 2006 132:375-380.
Martins C, Cavaco B, Tonon G, Kaye FJ, Soares J, Fonseca I. A Study of MECT1-MAML2 in Mucoepidermoid Carcinoma and Warthin’s Tumor of Salivary Glands. JMD 2004 6:205-10.
Tonon G, Modi S, Wu L, Kubo A, Coxon AB, Komiya T, O'Neil K, Stover K, El-Naggar A, Griffin JD, Kirsch IR, Kaye FJ. t(11;19)(q21;p13) translocation in mucoepidermoid carcinoma creates a novel fusion product that disrupts the Notch signaling pathway. Nat Genet 2003 33:208-213.
Cases of the Month Evaluation Coordinator: KarMing-Fung@ouhsc.edu
Copyrights reserved.